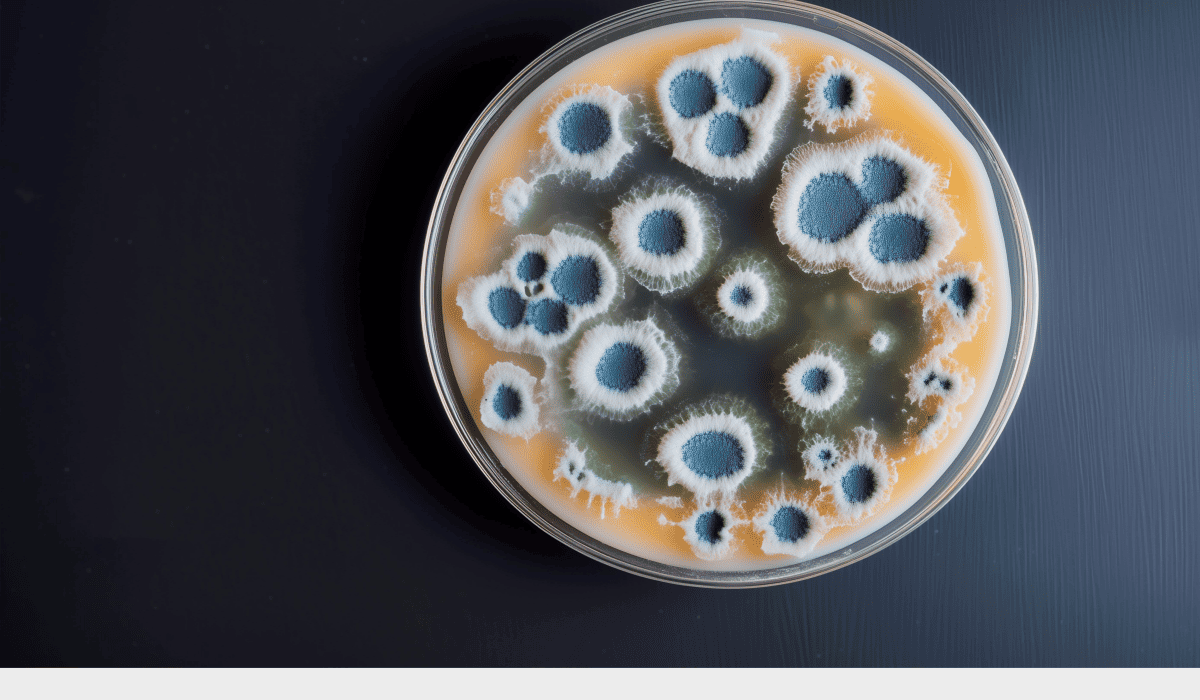
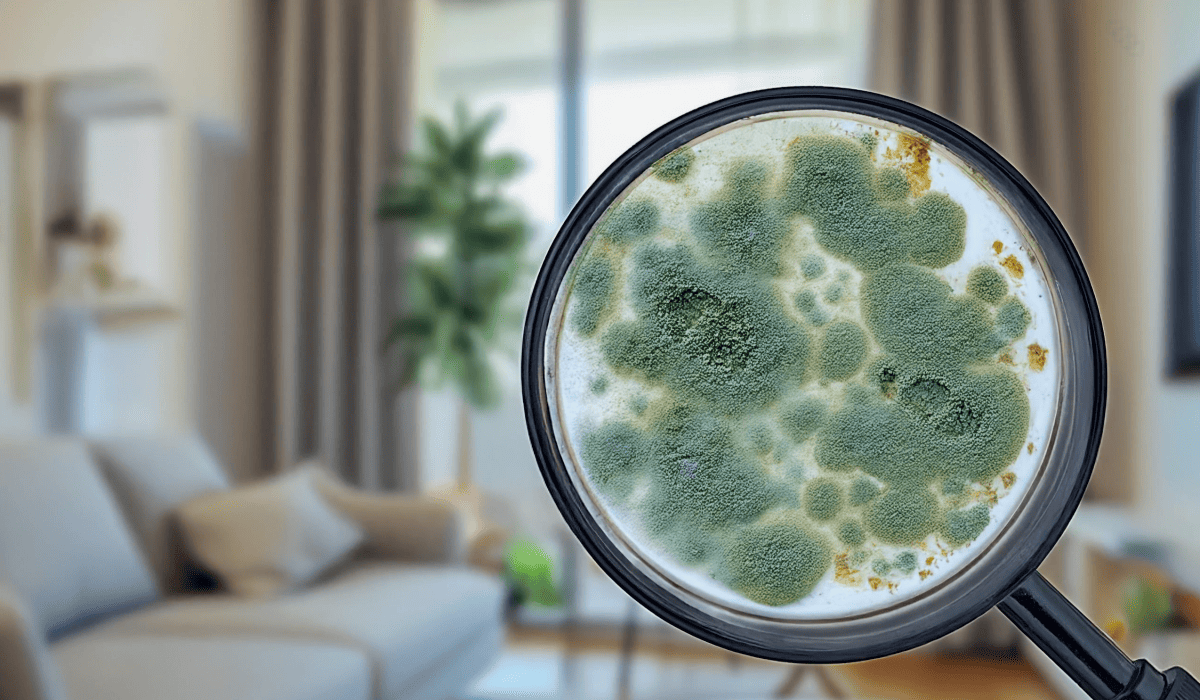

곰팡이 냄새 없애는 법 공간별 핵심 순서 정리: 집·옷·가전까지

저도 얼마 전 장마가 시작되니 옷장에서 퀴퀴한 향이 스멀스멀 올라와서 스트레스받았던 기억이 있어요. 방향제를 뿌려도 그때뿐, 근본적인 원인을 잡지 않으면 안 되겠더라고요. 그래서 오늘은 저처럼 여름철 실내 악취로 고민하는 분들을 위해, 원인부터 제거, 재발 방지법까지 곰팡이 냄새 없애는 법의 모든 것을 정리했습니다.
이 글을 읽으시면, 지긋지긋한 실내 냄새의 원인을 찾아내고 집안을 쾌적하게 만드는 확실한 곰팡이 냄새 없애는 법을 알게 되실 거예요!
1. 곰팡이 냄새, 어디서부터 나는 걸까?
효과적인 곰팡이 냄새 없애는 법은 그 근원지를 찾는 것에서 시작합니다. 곰팡이는 눈에 보이지 않는 곳에서 포자를 퍼뜨리며 불쾌한 향을 만들어내요. 우리 집 악취의 주범이 될 수 있는 곳들을 알아보겠습니다.
- 1순위: 습기 많은 욕실, 주방 싱크대 하부
- 2순위: 환기가 어려운 붙박이장, 신발장
- 3순위: 결로가 생기기 쉬운 창틀, 벽지 구석
곰팡이는 어둡고 축축하며 공기가 잘 통하지 않는 곳을 정말 좋아합니다. 그래서 매일 물을 쓰는 욕실이나 싱크대 하부, 볕이 들지 않는 붙박이장이나 신발장 깊숙한 곳이 주요 서식지예요.
겨울철 결로가 맺혔던 창틀이나 벽지 모서리를 꼼꼼히 확인하는 것이 곰팡이 냄새 없애는 법의 첫 단계입니다.




2. 공간별 곰팡이 냄새 원인과 제거 순서
공간의 특성에 맞는 곰팡이 냄새 없애는 법을 적용하는 것이 중요합니다. 원인을 정확히 알아야 확실하게 악취를 잡을 수 있어요. 장소별 맞춤 솔루션을 알려드립니다.
- 욕실/주방의 곰팡이 냄새 없애는 법: 락스 활용
- 옷장/신발장: 내용물 모두 꺼내고 제습제/숯 비치, 마른걸레로 닦기
- 벽지/창틀: 마른 천에 소독용 에탄올 묻혀 닦아내고 완벽 건조
욕실이나 주방은 곰팡이 제거제나 락스를 이용해 닦아내는 것이 가장 효과적입니다. 옷장이나 신발장은 내용물을 모두 비운 뒤, 마른걸레로 내부를 닦고 습기제거제를 넣어두는 것이 기본이에요.
벽지에 생긴 얼룩은 소독용 에탄올을 이용하면 번짐 없이 제거할 수 있는데, 이것이 벽지의 곰팡이 냄새 없애는 법입니다.




3. 집안 전체에 퍼진 냄새 없애는 실내 관리법
💡곰팡이 냄새를 없애는 실내 관리법은 아래를 참고하세요!
이미 집안 공기 중에 퀴퀴한 기운이 퍼졌다면, 실내 공기를 정화하는 것이 집안 전체의 곰팡이 냄새 없애는 법입니다. 악취 분자를 없애고 쾌적한 환경을 만드는 간단한 방법들이에요.
- 맞바람 환기: 하루 2번 이상, 10분씩 집안 전체 공기 순환
- 숯, 커피 찌꺼기 등 천연 탈취제 비치
- 양초 또는 인센스 스틱 활용
가장 중요하고 효과적인 방법은 '환기'입니다. 하루에 최소 두 번, 창문과 문을 활짝 열어 맞바람이 치게 하면 불쾌한 향과 습기를 함께 내보낼 수 있어요.
집안 곳곳에 숯이나 바싹 말린 커피 찌꺼기를 두는 것도 천연 탈취 효과가 뛰어납니다. 향초를 잠시 켜두는 것도 좋은 곰팡이 냄새 없애는 법이라 할 수 있습니다.

4. 옷에 밴 곰팡이 냄새 말끔히 없애는 세탁법
옷에 밴 퀴퀴함은 일반 세탁만으론 부족합니다. 옷에 특화된 곰팡이 냄새 없애는 법이 필요해요. 옷에서 나는 불쾌한 향을 뿌리 뽑는 특별 세탁법입니다.
- 과탄산소다 활용 애벌빨래: 가장 확실한 방법
- 헹굼 단계에서 식초 또는 구연산 소량 사용
- 세탁 후 즉시 건조, 건조기 또는 햇볕에 바싹 말리기
세탁기를 돌리기 전에, 따뜻한 물에 과탄산소다를 풀어 옷을 30분 정도 담가두면 원인균 제거에 효과적입니다. 헹굼 단계에서 식초나 구연산을 약간 넣어주면 섬유에 남은 향을 중화시켜줘요.
세탁이 끝나면 즉시 널어 습기를 완벽히 날려야 재발을 막을 수 있는 곰팡이 냄새 없애는 법이 완성됩니다.




5. 곰팡이 냄새 재발 방지 위한 생활 습관 5가지
가장 완벽한 곰팡이 냄새 없애는 법은 바로 재발을 막는 것입니다. 곰팡이가 살 수 없는 쾌적한 환경을 만드는 것이 최고의 예방법이에요. 꼭 기억해야 할 5가지 습관입니다.
- 습관 1: 샤워 후 욕실 문 열어두기
- 습관 2: 옷장, 신발장 문 수시로 열어두기
- 습관 3: 가구와 벽 사이 공간 띄우기
- 습관 4: 습도 관리: 근본적인 곰팡이 냄새 없애는 법
- 습관 5: 젖은 빨래 실내에 널지 않기
샤워 후에는 반드시 환풍기를 켜고 욕실 문을 열어 습기를 빼주고, 옷장과 신발장 문도 수시로 열어 공기를 순환시켜 주세요. 제습기나 에어컨 제습 기능을 활용해 실내 습도를 40~60%로 유지하는 것이 곰팡이 재발을 막는 가장 확실한 방법입니다.




오늘은 집안 곳곳의 곰팡이 냄새 없애는 법에 대해 알아봤습니다. 결국 곰팡이와의 전쟁에서 이기는 핵심은 '환기'와 '습기 제거'라는 두 가지 기본 원칙을 꾸준히 지키는 것이에요.
오늘 알려드린 방법들을 통해 쾌적하고 건강한 여름을 보내는 데 실질적인 도움이 되었으면 좋겠습니다 :)








'[Tip] 생활정보' 카테고리의 다른 글
| 베란다 곰팡이 제거법 제대로 하려면 반드시 확인할 3가지 (2) | 2025.07.09 |
|---|---|
| 건강한 아침 식단 구성 전 꼭 알아야 할 영양 균형 팁 (2) | 2025.07.07 |
| 개인신용점수 조회, 숫자만 보지 말고 이 기준까지 체크하세요 (2) | 2025.07.03 |
| 나이스 신용점수 조회, 구간만 알아도 대출 가능성 달라집니다 (1) | 2025.07.03 |
| KCB 신용점수 조회 가능한 곳, 공식 채널만 정리했습니다 (1) | 2025.07.02 |